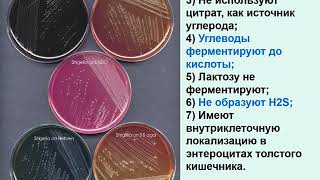

СКОЛЬКО ЛЕЖАТ ПОСЛЕ ЗАМЕРШЕЙ БЕРЕМЕННОСТИ В БОЛЬНИЦЕ ЧИСТКИ
После замершей беременности, в случае назначения процедуры чистки матки, обычно требуется госпитализация в больницу. Продолжительность пребывания в больнице может сильно варьироваться в зависимости от различных факторов, таких как физическое состояние матери, наличие осложнений, методы, применяемые при чистке, и индивидуальные особенности организма.
Обычно после процедуры чистки при замершей беременности больничное лечение продолжается от нескольких часов до нескольких дней. В первые часы или дни после процедуры могут потребоваться наблюдение и рекомендации врачей для обеспечения безопасности и физического восстановления.
Если вы ожидаете проведение процедуры чистки после замершей беременности, то рекомендуется обсудить с врачом ожидаемую продолжительность госпитализации и рекомендации по уходу после выписки, так как индивидуальные особенности случая могут повлиять на конкретные сроки лечения и восстановления.
Замершая беременность на 6 неделе. Что делать после замершей беременности. Отвечает Гузов И.И.
Выделения после замершей и чистки - это месячные или нет? Нужно ли проходить обследование? Гузов И.И
ЧИСТКА при замершей беременности. Всё о наркозе
Беременность после замершей. КОГДА можно БЕРЕМЕНЕТЬ после замершей беременности. Гузов И.И.
Когда можно беременеть после замершей беременности и выскабливания? Отвечает Гузов И.И.
1344 Выделения после выскабливания матки после замершей беременности
Планирование беременности после замершей. Когда можно беременеть после замершей беременности?
Замершая беременность / Признаки замершей беременности
Выделения после чистки. Через 2 недели после чистки усилились выделения, потом прошли -это месячные?
ВЫСКАБЛИВАНИЕ. Всегда ли нужно выскабливание при замершей беременности. Гузов И.И.